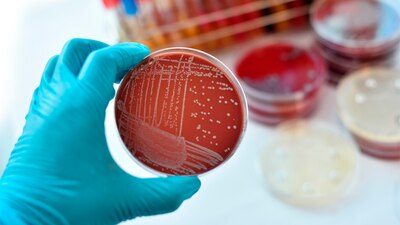
Al 29 de noviembre, se contaba con 15 casos confirmados y cuatro probables, en cuatro unidades médicas del Edomex

La Secretaría de Salud Federal emitió una alerta epidemiológica debido a un brote de Infección del Torrente Sanguíneo (ITS) causado por Klebsiella oxytoca, una bacteria relacionada con la posible contaminación de Nutrición Parenteral (NPT) o insumos utilizados en su aplicación.
Las infecciones por Klebsiella son un problema de salud pública importante, principalmente en el ámbito hospitalario, debido a su frecuencia, gravedad y resistencia a los antibióticos, lo que hace que el tratamiento sea más difícil.
Por ello, es fundamental implementar medidas eficaces de prevención y control para reducir el riesgo de infección y garantizar que los tratamientos seanefectivos.
Klebsiella oxytoca es una especie de bacteria gram-negativa, aerobia, noesporulada y con forma de bastón; que pertenece al género Klebsiella. Seencuentra comúnmente en el tracto gastrointestinal de humanos y animales, así como en el medio ambiente. Es una bacteria oportunista que puede causar infecciones en personas con sistemas inmunes debilitados.
¿Qué sabemos hasta ahora del brote en México de Klebsiella oxytoca?
El pasado 28 de noviembre de 2024, la Dirección de Información Epidemiológica, informó la notificación a través de la Red Hospitalaria de Vigilancia Epidemiológica (RHOVE) sobre casos de infecciones del torrente sanguíneo (ITS) en tres unidades médicas de segundo nivel de menores de edad con antecedente de haber recibido nutrición parenteral a partir del18 de noviembre a la fecha, en unidades de atención de salud tanto públicas y privadas.
La nutrición parenteral total (NPT) es un método de alimentación que rodea el tracto gastrointestinal. Se suministra a través de una vena, una fórmula especial que proporciona la mayoría de los nutrientes que el cuerpo necesita.
Al 29 de noviembre, se contaba con 15 casos confirmados y cuatro probables, en cuatro unidades médicas del Estado de México (tres públicas y una privada).